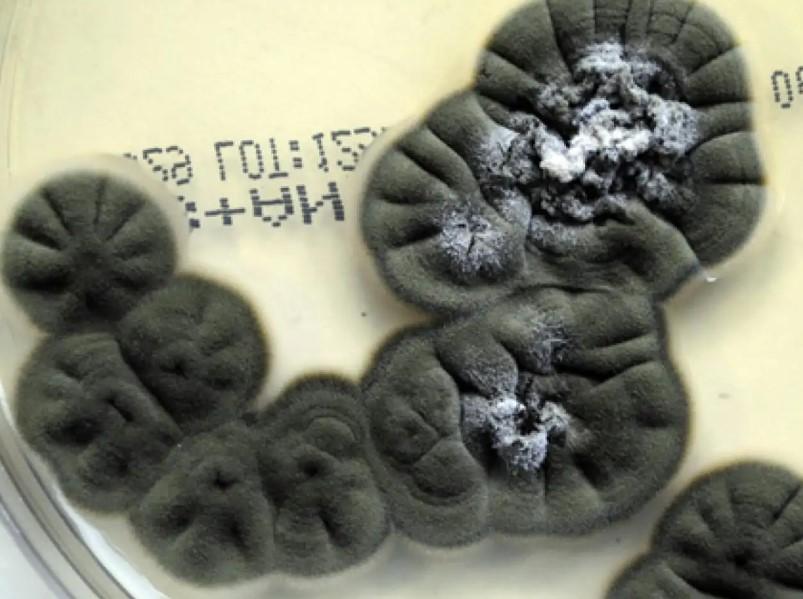

Mundo, 10 julio 2025 (ATB Digital).— ¿Qué conceptos se te vienen a la cabeza cuando piensas en Chernóbil? Quizás sea central nuclear, desastre, radiación, letalidad o lugar inhóspito. Y no estarían mal: se trata de un ambiente contaminado por radiación donde, incluso, es raro encontrar insectos. Pero es curioso ya que, a pesar de estar abandonado desde hace décadas… sigue habiendo vida en él. En las sombras de este entorno tan hostil, crece un hongo negro que no solo sobrevive a la radiación, sino que se alimenta de ella.
Su nombre científico es Cladosporium sphaerospermum, pero algunos lo llaman “el hongo fotosintético de la oscuridad”. Aunque suene como si se tratase de una criatura sacada de una novela de ficción, es un organismo muy real y que crea una gran curiosidad entre el panorama científico. Y no solo porque desafiase lo que creíamos posible sobre la vida en la Tierra, sino porque también podría ser útil a la hora de salir de ella.
Un superviviente de las sombras
Este curioso hongo fue descubierto en uno de los lugares donde, para ser sinceros, menos se esperaba descubrir algo: en las ruinas de la central nuclear de Chernóbil, en Ucrania. Tras el desastre nuclear de 1986, la zona se convirtió en un entorno tan contaminado por la radiación que se volvió inhabitable para la mayoría de las formas de vida. Pero, sorprendentemente, este hongo no solo resistió esas condiciones, sino que prosperó en ellas.
De hecho, a diferencia de otros organismos que intentan escapar de la radiación, Cladosporium sphaerospermum parece buscarla. Se ha observado que crece más rápido en zonas con mayores niveles de radiación gamma, lo cual llamó la atención de los científicos. ¿Cómo era aquello posible? Pues bien, la respuesta resultó recaer en un pigmento que nosotros conocemos muy bien: la melanina.
La radiosíntesis
Como bien sabemos, la melanina es la sustancia que está presente en nuestra piel y que nos protege parcialmente de los rayos ultravioleta del Sol. Pero en este hongo, este pigmento adquiere una función muy diferente: es como una especie de antena que capta la radiación ionizante, como la gamma, y la transforma en energía química que el hongo puede utilizar para crecer.
Este proceso, al cual algunos científicos llaman “radiosíntesis”, se asemeja a la fotosíntesis de las plantas, pero con una diferencia clave: mientras las plantas usan la luz solar, el hongo usa este tipo de radiación invisible. La melanina absorbe esa energía radiante y, a través de reacciones bioquímicas en la célula del hongo, convierte parte de esa energía en compuestos que le sirven como “combustible” para su metabolismo.
Por hacer una analogía más cercana, podríamos decir que este hongo “come” radiación de la misma forma que las plantas “comen” luz solar. Por supuesto, no es exactamente lo mismo a nivel molecular, pero el concepto general es muy parecido: convertir una forma de energía dañina para muchos en una fuente de vida.
Rumbo a Marte
Y, curiosamente, uno de los usos más prometedores de este hongo está… fuera de este mundo. Y es que la radiación es uno de los grandes obstáculos de la exploración espacial. Fuera del campo magnético de la Tierra, los astronautas están expuestos a altos niveles de radiación que podrían causarles daño a nivel celular, enfermedades e, incluso, cáncer. Por ello, para colonizar Marte o ir más allá, necesitamos nuevas formas de protegernos.
Y aquí es donde entra nuestro protagonista. En el año 2020, un experimento llevado a cabo en la Estación Espacial Internacional demostró que este hongo era capaz de reducir los niveles de radiación en su entorno. De hecho, se observó que, incluso una capa delgada, de apenas 2 milímetros, era capaz de bloquear una parte significativa de la radiación. ¿Te imaginas un hábitat marciano cubierto de una “piel” de hongo? Sería como un escudo biológico y autorreparable, que crecería con el tiempo y se alimentaría de lo que para nosotros sería letal.
Más allá del espacio
Pero las posibles aplicaciones de este hongo no terminan en Marte. En la Tierra, los investigadores también están explorando cómo la melanina de estos hongos podría usarse en tratamientos médicos para personas expuestas a radiación, como pacientes de cáncer que reciben radioterapia. Además, también se estudia su potencial en biotecnología, como la creación de materiales que cambien su comportamiento al entrar en contacto con distintos tipos de radiación.
Incluso, hay quienes imaginan usar hongos como sensores biológicos de radiación, o como parte de nuevos sistemas de producción de energía. Y, aunque es cierto que estamos lejos de tener hongos “productores de electricidad”, el principio de transformar energía peligrosa en energía útil ya está en marcha, y este hongo, no cabe duda, nos está mostrando cómo.
Fuente: National Geographic España